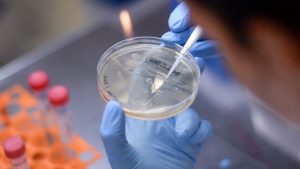

آزمایش فاز اول کارآزمایی بالینی واکسن کرونا در استرالیا
اولین کارآزمایی خارج از آمریکا، روی واکسن ضدویروس کرونای شرکت نواواکس در استرالیا انجام میشود. برای این کار از همکاری شرکت نوکلئوس استفاده شده است.
شرکت نواواکس (Novavax) از شرکت نوکلئوس (Nucleus) درخواست کرد تا کارآزمایی بالینی فاز اول واکسن ضدویروس کرونا را در خارج از آمریکا آغاز کنند.
به عنوان بخشی از رقابت جهانی برای تولید واکسن ضدکرونا، این شرکت فاز اول آزمون بالینی روی واکسن حاوی نانوذرات پروتئین سنبله نو ترکیبی ویروس SARS CoV 2 را در ملبورن و بریزبن طی هفتههای آتی آغاز خواهد کرد.
مدیرعامل شرکت نوکلئوس گفت: نوکلئوس تاریخ غنی برای فاز اول کارآزماییهای بالینی و همچنین همکاری طولانی مدتی با شرکت نواواکس دارد.
این سومین کارآزمایی واکسن کووید 19 در جهان بوده و اولین آزمایش کرونا در استرالیا محسوب میشود. ما برای انجام این آزمون بالینی آماده هستیم تا به سرعت این آزمون بالینی را روی انسان طی هفتههای آتی پیادهسازی کنیم.
او همچنین اضافه کرد: با ظرفیت موجود برای انجام کارآزمایی بالینی در مبلورن و بریسبن، ما میتوانیم فاز اول این آزمون را به سرعت برای نواواکس انجام دهیم.
تلاشهای اولیه انجام شده برای تولید واکسن برای سارس و مرس، به محققان شرکت نواواکس این امکان را داده است تا درک مناسبی از ویروس کرونا داشته باشند و بتوانند براساس این آشنایی برای تولید واکسن بر علیه کووید 19 اقدام کنند.
استنلی سیارک، مدیرعامل شرکت نواواکس تصریح کرد:رقابت جهانی برای توسعه واکسن بر علیه ویروس کووید 19 باعث شده تا شناسایی و انتخاب واکسنی بهینه و ایمنی تسریع شود. ما خوشحالیم که نوکلئوس شریک طولانی مدت ما، توانسته است تا براساس جدول زمانی جلو رود.
انتظار میرود که کارآزمایی بالینی روی واکسن کووید 19 در اواسط ماه می آغاز شود و بررسی نتایج ایمنی و ایمنیزایی نیز در ماه ژوئیه صورت گیرد.
مقیاس کار در این کارآزمایی به شرکت نوکلئوس این امکان را میدهد تا فوریت مطالعات واکسن کووید 19 را بدون وقفه در دیگر کارآزماییهای بالینی به کار گیرد.
شرکت نوکلئوس بهعنوان شریک کلیدی در توسعه این واکسن، نقش مهمی در کمک به حل مشکل شیوع بیماری کرونا در جهان دارد.